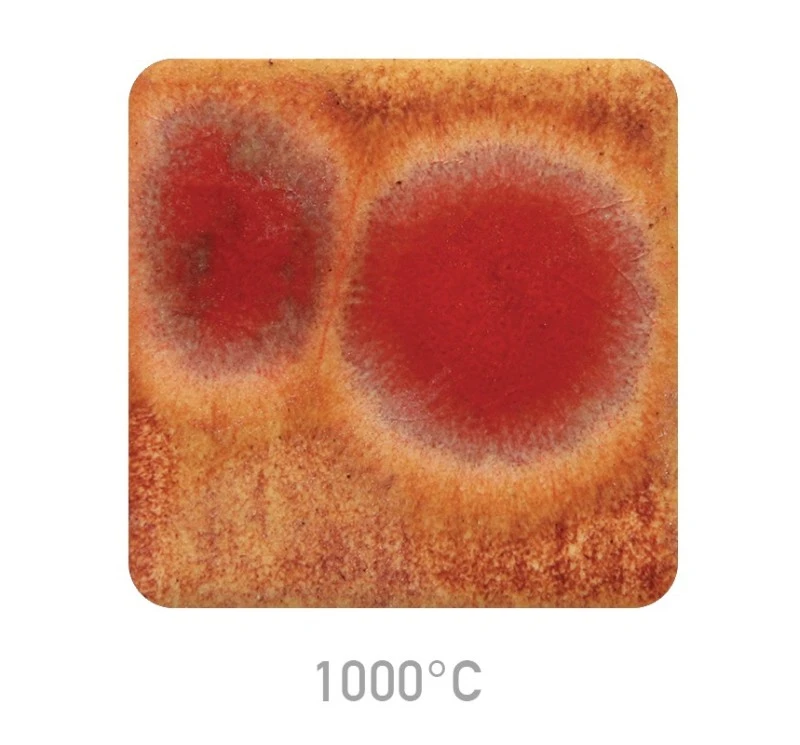

MAYCO Szkliwo Jungle Gems CG-972 Dragon's Breath 118 ml
MAYCO Szkliwo Kryształowe Jungle Gems CG-972 Dragon's Breath 118 ml
MAYCO CG-972 Dragon's Breath to efektowe szkliwo kryształowe z serii Jungle Gems, które tworzy na powierzchni ceramiki niezwykle dynamiczny i gorący efekt kolorystyczny. Ta glazura została zaprojektowana, aby naśladować intensywny, płomienny ruch, idealny do uzyskania dramatycznych akcentów dekoracyjnych. Szkliwo dostępne jest w pojemności 118 ml.
Charakterystyka Wizualna:
W masie szkliwa bazowego zawieszone są drobne fragmenty szkła (kryształy), które ulegają spektakularnej transformacji w piecu:
Baza Kolorystyczna: Szkliwo bazowe jest półkryjące, w ciepłym odcieniu pomarańczowym/rudym.
Efekt Kryształów (Wypał na ok. 1050°C): Podczas wypału kryształy roztapiają się i "rozkwitają", tworząc większe, płynne plamy koloru. W przypadku Dragon's Breath są to rozproszone, kontrastowe akcenty w intensywnych barwach ognistej czerwieni, głębokiego granatu oraz żółci, co daje efekt gorącego, płynącego ognia. Efekt końcowy jest błyszczący i bardzo wyrazisty.
Wpływ Wyższej Temperatury: Szkliwo można wypalać do wyższych temperatur (np. 1222°C), ale ze zwiększoną ostrożnością. W takich warunkach kryształy silniej się roztapiają, zwiększając płynność i ewentualną transparentność bazowej glazury.
Specyfikacja Techniczna i Aplikacja:
Optymalny Zakres Wypału: Najlepsze i najbardziej widowiskowe efekty uzyskuje się w niskim zakresie temperatur, optymalnie przy ok. 1050°C.
Aplikacja:
Szkliwo należy energicznie wstrząsnąć i dokładnie mieszać przed każdym nałożeniem, aby zapewnić równomierne rozmieszczenie kryształów.
Zaleca się nakładanie 2–3 warstw pędzlem na biskwit wypalony na ok. 1040°C.
Wskazówka: Ze względu na dużą płynność kryształów podczas wypału, należy je aplikować z dala od dolnej krawędzi pionowych wyrobów, minimalizując ryzyko spłynięcia i uszkodzenia półki piecowej.
Bezpieczeństwo Produktu:
Szkliwo jest bezołowiowe i spełnia normy bezpieczeństwa (Food Safe).
Ograniczenia Użytkowe: Ze względu na silnie teksturowaną i nierówną powierzchnię tworzoną przez roztapiające się kryształy, szkliwo nie jest zalecane do ceramiki stołowej mającej stały kontakt z żywnością. Rekomendowane jest do wyrobów dekoracyjnych i artystycznych.